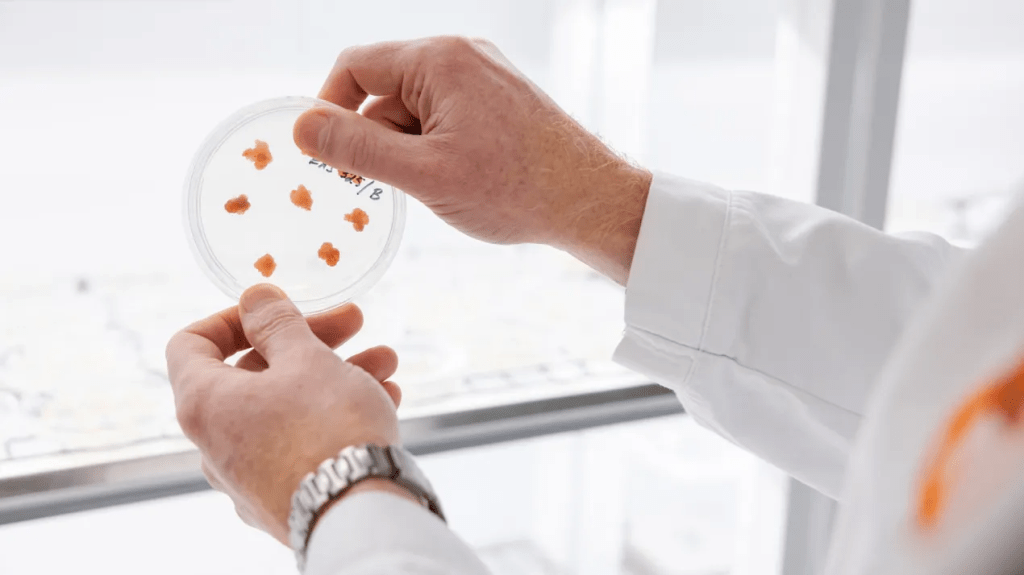

Portfolio – excerpts from design journeys
Commercial design work for businesses is usually meant to bring value to a certain matter. This is to happen with assigned resources, within the defined scope, in the agreed cost framework and according to a given schedule.
But there are “buts”. Twists, dissentings, delays, full turns and other uncertainties will surely come up. The project may change its shape or scope as the work progresses. Or it may be canceled in whole, or in part. The cost frame can change. People will leave the project. Anything can happen on the journey.
Do what you love
But: that journey is exactly the point. Design work is a journey. If you love the twists and turns of design work, like I do, and if you love also everything that comes with it – not just the end result – then you are on the right journey.
About this portfolio
I have failed to systematically record every design work I have been taken part in. When I have had enough diligence, I have saved samples to prepare them on display “later”. Because of that many great design works remain unseen.
Of those that I’ve managed to save properly I have collected the most memorables as my portfolio. Not all, but varying and different samples – not in any particular order of importance or value.
Creativity in design

What is creativity? Does it include any information of its own scope? Does it have a measure, a quantity or any common reference value?
I see human creativity as sensitivity, and skills, to think and create things that do not yet exist. We typically tend to associate creativity within areas like arts, architecture, literature, music, science, design .. etc. But creativity occurs in all fields of human life. And actually creativity has been – and still is – the basis for our survival and evolution.
Read here more about creativity?
Well, anyway .. I’ll leave it up to you to judge the creativity involved in these works.
. . . . . . . . . . . . . .

VTT – National Institute for Research and Technologies is an institute owned by Finnish state. The “VTT” letter abbreviation is an established appearance of the finnish words “Valtion Teknillinen Tutkimuskeskus”. In case of a need for independent research-based information, VTT is The One to approach and whose authority and assessments are widely trusted.
What happened?
Brand creation. Comprehensive rebranding, visual rebuild, communication refreshment and applications remake for an iconic and widely respected – but outdated – research institute.
Read more about this design journey with VTT

Read more about this design journey with VTT
. . . . . . . . . . . . . .

Comptel Corporation Telecom SAAS softwares. Finnish company a forerunner in SAAS business development; specialised in international telecommunication softwares. In Ai – way ahead of its time. Nokia acquired Comptel to merge it as a part of its Software business unit.
What happened?
Brand creation. Brand creation & applications. Design system, visual concepts, productions, material management, events, product launches, web design, illustrations, display ads, VFX productions.

















. . . . . . . . . . . . . .


S-Group & SOK, retail brands and stores. S-group is a customer-owned Finnish cooperative network of companies. It consists of 19 regional cooperatives operating in retail and service sectors. SOK, Suomen Osuuskauppojen Keskuskunta, is a central cooperative owned by regional cooperatives.
In numbers: 41 000 employees, over 2 000 outlets and stores, 2.6 million customer members, sales 14,5 billion euros in 2023 and operating profit 450 MEur in year 2023.
Services in the supermarket trade, department and speciality stores, service stations & stores and fuel sales, travel and hospitality business, hardware trade, car dealerships, agricultural outlets and banking service S-Bank.
Read more about design journeys with S-Group ( in Finnish )

What happened?
S-Group retail brands and stores. Retail brands ( S-Market, Prima, Alepa, Sale ) brand creation and design systems, retail stores milieu design remake, advertising concept update, and visual language and communication refreshment, customer communications service design.

. . . . .

. . . . .


. . . . .


Read more about design journeys with S-Group ( in Finnish )
. . . . . . . . . . . . . .


Finnish Military Force, National Defence is among the most significant in Western Europe. General conscription in Finland guarantees a steady stream of new personnell every year to be trained for military tasks – that no one wants to actually use.
In addition to military training there are also a lot of tasks for permanent personnel in other than military tasks. During years a shortage of that personnel has evolved.
What happened?
Recruit activities. Personnell recruitment campaign for other than military jobs. We designed the concept for a recruitment campaign online and print implementations targeting the civilian tasks of the army. There is a need of professionas for medical care, building and maintenance, machinery upkeep .. etc.
Concept and visual design for web site, ad campaign, illustrations and media solutions.



. . . . . . . . . . . . . .

Senaatti Properties Government real estate and premises. Senaatti oversees, manages, develops and maintains a diverse portfolio of Finnish covernment estates. These assets range from offices to Finnish Defence Forces’ premises.
Senaatti is also a pioneer in healthy working environments and serves as the main partner of the Finnish government in that respect.

Awareness of the effect of bad or good indoor air quality on working conditions, health and time spent at work in general was not at a very good level. A large-scale clarification and improvement program and the related communication work were started in the public administration working environments.
What happened?
Raising awareness of indoor environment conditions. Communication concept and advertising launch campaign. Campaign concept, communication concept, visual concept. Content creation and graphic design, campaign management and media applications. Web design, presentations, publications and sub campaigns. Media applications, photoshoots, image creation and vfx productions. Videos, animations and screen graphics. Radio ad campaign, print applications and material management.




. . . . . . . . . . . . . .


Fastems factory automation. Automation solutions for high-mix CNC manufacturing. And robotic solutions with production planning and execution software. In short high-end expertise in factory automation and everything that comes with it.
Do you know how state-of-the-art heavy industry factories work? Well I do – after designing and producing these factory presentation and sales materials. Factory automation in itself doesn’t sound very media-sexy. But seeing the customer base, and who around the world is ready to pay for this excellence, then you’re on the point. For example, it is not the most modest detail that this know-how is utilized in the production of F35 stealth fighters.
What happened?
Sales material. Concept for visualization of factory planning, design work, publications, VFX design work management, display advertising, videos, illustrations.







. . . . . . . . . . . . . .


“Työ 2.0 Lab”. Joint workspace concept. Co-working space concept and location estates. “Työ 2.0 Lab” was born from a dream to do and learn things together. In other words to radicalize the rigid operating methods of public administration office and teamwork practices by making shared workspaces more widely available. “Työ 2.0 Lab” offers a meeting place and working facilities that crosses administrative and sector boundaries..
What happened?
Interior and environment visuals, signage, web design & UI, display ad campaign, social media, marketing and ad campaign. Graphic design, concept design, illustrations, media applications and productions.


. . . . . . . . . . . . . .

Comptel Corporation A Finnish software company specialised in telecommunication softwares. In Ai – tech way ahead of their time. The company was founded based on a discontinued business unit of a Finnish telephone company. Nokia acquired Comptel later on to merge it as a part of its Nokia Software business unit.
Nexterday North. An annual “anti-seminar” bringing together the disruptors of the telecom and communications industry. Industry event and networking arena for professionals in co-operation with Slush; focused on getting communications service providers to stop thinking about their digital transformation strategies and actually start implementing them.
What happened?
Event visual concept and materials. Promotion ad campaign for tickets pre sell and event registration. Concept for contents and web design. Event applications, VFX productions & event stage experience, visual design & design system, media applications, display advertising.











. . . . . . . . . . . . . .


Asiakastieto, business and consumer information. Finland’s leading provider of digital business and consumer information services. GDPR is The General Data Protection Regulation in a European Union regulation on information privacy.
What happened?
GDPR product launch campaign. Visual and content concept creation, graphic design, radio campaign, illustrations, material production management.


. . . . . . . . . . . . . .


Finavia, national airport oprerator is a Finnish national airport operator enabling international flight connections through its national airport network in Finland. You may have visited in Helsinki Airport which is awarded for many times over of the best worldwide customer experience.
In the mid-2000s the Finnish Civil Aviation Authority was divided by a political decision into two separate parts: the Aviation Regulatory Authority and a state-owned company operating airports commercially.
What happened?
Brand creation. The new airport operator was named Finavia. And it needed all the brand credentials. When I got the privilege for this brand creation work, I set myself the goal of an end result that will remain in the history of Finnish brand design. I would argue that it worked out quite nicely.
Brand design system build-up and upkeep. Logo design, graphic design for brand applications, materials management, layout productions, web design, print productions.
Read more about design journey with Finavia ( in Finnish )



Read more about design journey with Finavia
. . . . . . . . . . . . . .

Junttan hydraulic piling equipments is specialised in hydraulic state-of-the-art piling equipments. World’s leading pile driving rigs, multipurpose piling and drilling rigs and hydraulic impact hammers .. etc. In short heavy machinery related in to all foundationing.


What happened?
Logo creation and brand design system. Visual and content concept for brand creation. Brand applications, logo design, presentation materials, web design, brochures, illustrations.



. . . . . . . . . . . . . .

Rannikkosotilaskodit, well-being of military reserve. “Coastal military home association” works to increase the free time enjoyment of conscripts serving in the maritime and coastal defence Forces and those participating in reserve exercises.


What happened?
Sometimes it’s downright refreshing if the assignment is precisely defined. Within its framework and relying on it, you can stick to a precisely focused procedure. Produce the expected design to the best of your ability and pushing its limits. This was a design work just like that: to create a logo/symbol and fundaments for identity.
The round shape of the symbol is a reference to the round badge of the Defense Forces, or cockade. I created the letters “R” and “S” from the words “Rannikko” and “Sotilaskotiyhdistys” for the emblem. The blue-green coloring comes from the Marine and Land Forces, and the letter pattern is also surrounded by blue “sea” and green “continent”. The pattern formed by the letters adapts to the diversity of islands, capes and coves typical of the Finnish coast.
Read more about this design ( in Finnish )
. . . . . . . . . . . . . .

The University of Helsinki, rector’s office manages plans for budgeting and fundraising for long-run activities. The University is the oldest and largest institution of academic education in the country. 40,000 international students and researchers. In international rankings typically ranks in the top 1 %.
What happened?
Strategy period infographics. The university’s funding is planned in four-year periods. The planning of the next four-year period and the preparation of funding applications begin already when the activities of the previous period have just begun. Funding negotiations with various ministries last the entire previous funding period.



For this activity, we produced a series infographics for the University’s rector’s office to help negotiate and visualize the relationship between the phases of the funding period and the University’s other strategic work.
We also produced infographics for the basic strategy work to describe the relationship between the University’s strategy and vision. I worked on this visualization for a long time with the University’s communication team. At first we couldn’t find a suitable way to visualize the matter. Many different visual approaches were tried, until I suggested that we’ll build the most essential one – that is, the student – at the center of the visualization. That realization helped us to take the work further and into the finish.

. . . . . . . . . . . . . .

Alma Media business media services. Digital solutions business unit focused on b2b media publications and paid media solutions. Media channels outreach the majority of Finnish experts and final decisioners in business life.


What happened?
B2B advertising customer acquisition campaign. Concept design, graphic design, display advertising and campaigns. Content marketing, design & tone-of-voice, ad traffic management solutions, social media, digital and print media applications.
“Digimarkkinointia yksinkertaisesti” ( “Simply digimarketing” ) is a communication concept created to make sense to a complex sales pitch set. Breathtakingly long explanations about the versatility and superiority of advertising services were reduced to a simple level. It makes selling to new customers much more approachable and easier.

This is a “school book example” of designing a content concept. Communication strategy and message hierachy at first, and then applying all communication and media solutions in practice.

. . . . . . . . . . . . . .

Marimekko & Stora Enso, partners in packaging. Marimekko is a legend in Finnish design. Armi Ratia’s legacy continues. Kirsti Paakkanen, another Finnish iconic figure, gained control of the company. The company’s role as a design icon received a worthy continuation.
Our many years of cooperation with Stora Enso led to interesting projects. We started to develop a concept of food packaging boards’ suitability for non-food uses. In practise this means industrial level applications and widely engineered production arrangements.
What happened?
We attracted a Finnish company and design icon, Marimekko, as a partner for this venture. Kirsti Paakkanen, managed the company at the time. With her and her team we developed a few applications to test carboard packagings in practice with non-food consumer products. One example of these experiments is the Marimekko’s “Jokapoika” shirt consumer packaging series.

Another design implementation is a picnic set designed as a stakeholder and business gift with Marimekko’s “Unikko” design theme. “Unikko” is an design-icon in the Finnish fashion industry. The gift box is made of flute cardboard and it has a complete meal set for picnic use. All made of StoraEnso materials, naturally.


. . . . . . . . . . . . . .

Corporate identity design, brand creation and design systems. How companies, and such, appear visually and how they present themselves to the rest of the world. That is a major part of corporate design industry. Designing a logo or a company symbol or a product logo, or establishing and implementing a comprehensive design systems. There is always a designer or a group of designers, or a team, at the heart of the design work.
And I have done that. The design outputs are sometimes prominent and publicly revealed. Or, as is often the case, that takes place hidden from the public. The design development can be subtle maintenance and upkeeping work by its nature. I love it both ways.
What happened?
Logo design. Logo design is one area in corporate identity, and quite common task for designers. I’m not sure how many logos I’ve designed, but quite many. Here are some samples. And as is often the case, a logo is just the tip of the iceberg of a larger corporate identity design. Many of these shown here are also shown elsewhere on this website in more details.


















One typical task of corporate identity and logo design is to refresh the existing logotype as the basis for a new look. “Koskisen” forest industries is a typical case of this kind.
. . . . . . . . . . . . . .

YIT paving, seasonal workers comms concept. Yit is the largest of Finnish construction companies, also significant in North Europe. YIT develops and builds apartments, business premises and entire areas. Also specialised in demanding infrastructure construction and paving.

What happened?
A communication concept and publications for seasonal workers. Paving work can only be done in the summer season. Round-the-clock days are a norm during the working season. And the winter season is spent away from Finland. In order to reach these professionals, we developed a communication concept and publication tools to approach permanent employees. That need to happen well in advance of the start of the season. Then it is assured that enough working staff is available when paving projects begin.

Paving business is much of rocks and paving roads, rock’n road.
Internal communication concept design, content creation, logo design, magazine layout design, publication production works, photoshoots, infographics.




. . . . . . . . . . . . . .

Cloudia, eProcurement solutions. Cloudia provides digital procurement and contract lifecycle management solutions. A complete suite of Source-to-Contract services for both private and public sector organizations.
The basic condition for concluding legal contracts is trust and credibility. Our observation was that stories of these fundamentals is the key to an excellent communication concept. It communicates about the nature of the procurement contracting as a phenomen. It also opens up Cloudia’s trusted role as an enabler in the procurement process.
What happened?
Customer marketing comms concept, web site, presentation materials and media campaign for brand awareness and new customer acquisition.
. . . . . . . . . . . . . .


Netello, business Internet services. Netello is an Finnish online business solution service provider. Internet marketing and online partner for small and medium-sized companies.
What happened?
Content marketing campaign. Communication and campaign concept, visual design, VFX productions, display ad campaign, online videos, infographics and illustrations.


. . . . . . . . . . . . . .

Photograpic design and photo productions. Photo shooting direction, image editing, staging, casting and numerous pre- and post-production works are the basic tasks of a visual designer.
I have been involved in a lot of photo productions, on locations indoor and outdoor and in studio environments. It is unfortunate that I have managed to save only a fraction of these projects here as samples.
What happened?
Multiple photo productions for various clients. The photos I present here are uniquely produced imagery for marketing, advertising, product promotion, communication and brand use for various clients.























. . . . . . . . . . . . . .

Packaging and haptical items design & production
We are dominated by digital channels, social media, online shopping and services; and now even artificial intelligence. It may seem either old-fashioned or refreshingly different to talk about design and production of haptic – i.e. tangible – things. For me that has always been an object of interest and skill development.
The packaging and material industries, printing industries and hundreds of related service providing industries are still much more significant industries when it comes to tangible real life. The majority of products we use are stored, transported, distributed, presented, sold and consumed packaged. These industries and services are therefore significant industries and employment sectors worldwide. Their direct and indirect environmental effects are also extensive.
This means that expertise of design, production and value chains related to packaging are valuable knowledge capital. I have broad and deep experience related to packaging concepts and structures, layout design and related production, printing and manufacturing productions and supervision, as well as cooperation with subcontractors, the package manufacturing industry and print + post-processing industry and service providers.









. . . . . . . . . . . . . .

. . . . . . . . . . . . . . . . .
Helloyes .. Explorer, concept designer, art director, content creator and graphic designer.
”I belive that you should be yourself, since all other roles are already taken. If you have the opportunity to express an opinion, express your own.”
Thoughts, posts and opinions represent myself only.
. . . . . . . . . . . . . . . . .






































































































